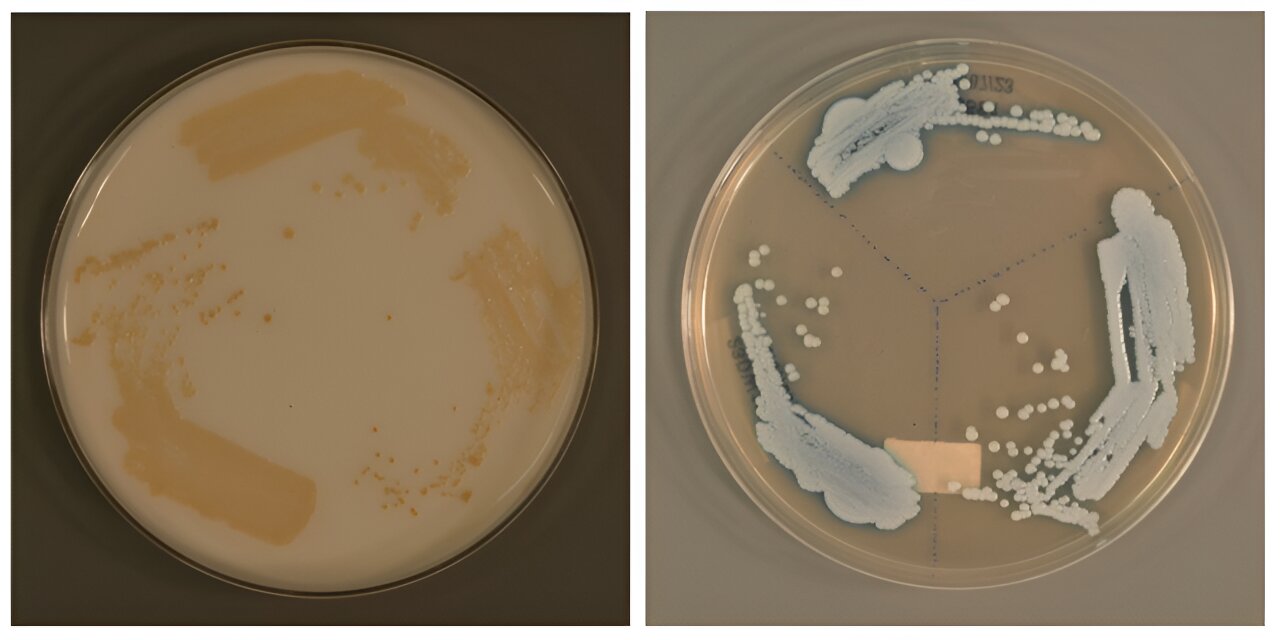
Новый тип Candida auris / © Genome Institute of Singapore (GIS)

Статьи по тегу #патогены

В анатомическом музее, среди старых медицинских образцов, ученые обнаружили следы вируса, который поразил жительницу Лондона почти 250 лет назад. Исследователи смогли восстановить его геном. Они утверждают, что на сегодня это …
Игорь Байдов
16.02.2026

Группа американских исследователей изучила обитающие на мундштуках вейпов микроорганизмы и обнаружила среди них целый ряд грибков, большинство из которых оказались потенциальными патогенами.
Во многих исследованиях о негативном влиянии вейпинга на …
Юлия Трепалина
15.08.2025

При смывании унитаза в воздух поднимается аэрозольный шлейф с микроскопическими частицами экскрементов и вредоносными микроорганизмами. Особенно эта проблема актуальна для общественных уборных, где высокая концентрация патогенов в воздухе способна привести …
Юлия Трепалина
18.02.2025

Ученые наблюдали своеобразную гонку вооружений между паразитом и хозяином, когда обнаружили, что грибок Beauveria bassiana «взламывает» иммунную систему плодовых мушек, заставляя ее уничтожать собственные клетки мозга.
По приблизительным оценкам, среди …
Любовь Соковикова
16.02.2025

Исследовательская группа из Боннского университета (Германия) обнаружила, что иммунные клетки «вынюхивают» патогенные микроорганизмы с помощью специальных компонентов врожденного иммунитета — так называемых Толл-подобных рецепторов, которые позволяют организму распознавать инфекции и …
Любовь Соковикова
15.11.2024

Мыть руки важно для предотвращения инфекций. Но насколько чисты раковины, которыми люди при этом пользуются? Недавнее исследование показало, что в биопленке — слизистой субстанции, которую порой можно обнаружить вокруг сливных …
Юлия Трепалина
13.08.2024
Популярные категории
Популярные статьи

Биология
Патогенные для человека бактерии выжили в марсианских условиях 05.02.2024
Медицина
Крышка унитаза не защитила от смываемых вирусов 29.01.2024
Медицина
Умывальники оказались рассадниками опасных микробов 13.08.2024
Медицина
Микробиологи рассказали о бактериальном вампиризме 17.04.2024
Медицина
Гендерно нейтральные туалеты оказались самыми грязными 02.05.2024
Медицина
Ученые открыли новый тип смертельно опасного грибка 06.08.2024
Антропология
Охотники-собиратели заплатили за земледелие вспышками чумы и гонореи 13.03.2024
Медицина
Ученые выяснили, как иммунные клетки «вынюхивают» патогенные микроорганизмы 15.11.2024
Биология
Грибок заставил иммунитет плодовой мушки уничтожить ее мозг 16.02.2025
Медицина
Вытяжная вентиляция снизила уровень патогенов в общественном туалете 18.02.2025